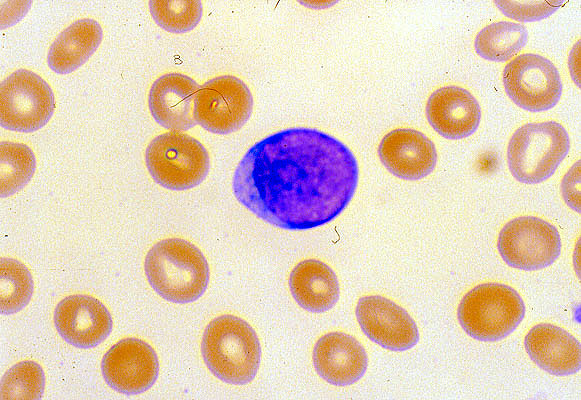

Leukemic blast, peripheral blood smear
Click picture to enlarge. Close window to return
This blast shows a very high N:C ratio, with scant agranular cytoplasm and an oval nucleus with finely dispersed, immature chromain. The morphologic appearance is not specific for lineage, and special studies would be needed to determine lineage.